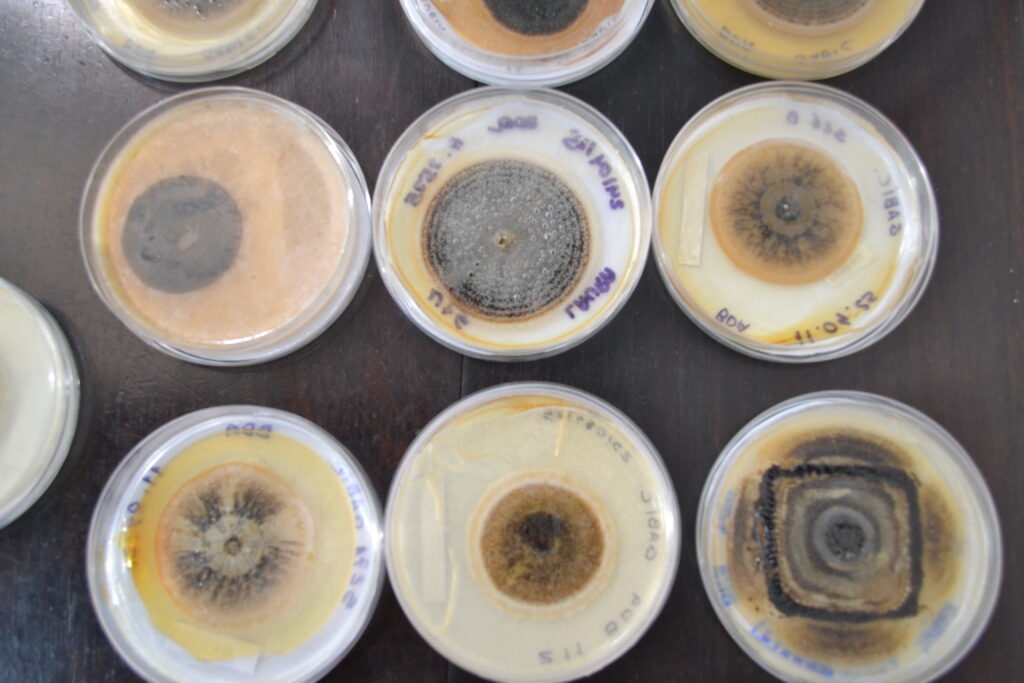

Portal UFRRJ > INSTITUCIONAL > Notícia Destaque > NAAC/UFRRJ celebra 5 anos fortalecendo a preservação e difusão do patrimônio cultural
NAAC/UFRRJ celebra 5 anos fortalecendo a preservação e difusão do patrimônio cultural
Arte Cultura Esportes | 02/10/2025 - 10:17
Evento contou com palestras e exposições, aproximando estudantes, pesquisadores e visitantes

O Núcleo de Articulação de Acervos e Coleções (NAAC) da Universidade Federal Rural do Rio de Janeiro (UFRRJ) completa cinco anos de existência em 2025, tornando-se um espaço essencial para promover, conservar e divulgar o patrimônio cultural junto à comunidade acadêmica.
A comemoração aconteceu nesta terça-feira (30/9) e contou com uma programação especial, marcada por palestras e exposições. Na parte da manhã, os estudantes, docentes e convidados puderam ouvir sobre a importância do NAAC em falas da coordenadora do núcleo, Andressa Esteves, e da coordenadora da Coordenadoria de Educação a Distância (CEAD) da UFRRJ, Gabriela Rizzo. Também estiveram presentes o pró-reitor adjunto de Extensão, Marcos Pasche, a pró-reitora de Extensão, Maria Ivone Martins, e o vice-reitor da UFRRJ, César Augusto da Ros.
Além disso, o evento contou com a participação da educadora museal do Museu Nacional, Universidade Federal do Rio de Janeiro (UFRJ), Aline Miranda, que compartilhou suas vivências e reflexões sobre os desafios da educação museal.
Durante a palestra, Andressa Esteves destacou a trajetória de evolução do NAAC ao longo dos seus cinco anos e ressaltou a expectativa de mudanças positivas para os próximos anos
“Primeiro tivemos aquela preocupação de organizar as coleções, preservar e ampliá-las, depois abrir para o público e pensar em dinâmicas para atrair convidados. Foi acontecendo ao longo do tempo , a gente sentiu a necessidade de melhorar a visitação, tudo isso lidando com custos. Isso foi fazendo com que o núcleo fosse saindo daquele caráter mais amador para uma coisa mais profissional”.
Para os projetos futuros, a coordenadora do NAAC enxerga uma oportunidade para a comunidade local em breve.
“A gente tem um projeto, de que em algum momento, ter a possibilidade de abrir os museus aos finais de semana para a população de Seropédica, para possibilitar uma programação cultural e histórica, sem que o morador da região precise ir muito longe”, disse Andressa.
Confira na galeria as fotos da cerimônia:








Na parte da tarde, o público foi convidado a prestigiar uma exposição comemorativa que reuniu acervos e coleções dos museus da universidade.
O evento aconteceu no Centro de Memória/Museu Casa do Reitor. Entre os destaques, estavam parte do acervo do Museu de Anatomia Patológica Carlos Tokarnia, Museu de Microscopia e Histologia, Museu de Zoologia, Museu de Química, Museu de Rochas e Minerais e Museu de Solos do Brasil.
Confira abaixo as fotos da visita à exposição NAAC – Caminhos entre Práticas e Saberes:

Serviço:
Para localizar os museus no câmpus Seropédica, acesse a ilustração a seguir:
Museu Casa do Reitor – Centro de Memória da UFRRJ
Localização – Câmpus Seropédica da UFRRJ: https://maps.app.goo.gl/KGEfsQRezv27zUU49
E-mail: centromemoria@ufrrj.br
Instagram: @cm.ufrrj
Museu de Anatomia Patológica Carlos Tokarnia
Localização – Anexo 1 do Instituto de Veterinária (antigo IBA ou PSA), câmpus Seropédica da UFRRJ: https://maps.app.goo.gl/NA9PWkWCBwU3t7ME6
E-mail: museutokarnia@gmail.com
Instagram: @museutokarnia_ufrrj
Museu de Solos do Brasil
Localização – Câmpus Seropédica da UFRRJ: https://maps.app.goo.gl/k5iT98wGgqPZMg9F9
E-mail: museusolos@ufrrj.br
Instagram: @msb.ufrrj
Museu de Zoologia
Localização – Instituto de Ciências Biológicas e da Saúde (ICBS), sala 10, câmpus Seropédica da UFRRJ: https://maps.app.goo.gl/VsE2VkjhUmTfBgwQ9
E-mail: museuzoologia@ufrrj.br
Instagram: @mzufrrj
Museu da Química Profª Aparecida Cayoco Ikuhara Ponzoni
Localização – Instituto de Química, sala 20, câmpus Seropédica da UFRRJ: https://maps.app.goo.gl/M3U26GFPSdvYjiV79
E-mail: museudaquimica@ufrrj.br
Instagram: @museudaquimica.ufrrj
Texto e fotos: José Davi, estagiário de Jornalismo da Coordenadoria de Comunicação Social (CCS/UFRRJ).
Edição: Michelle Carneiro, jornalista da CCS/UFRRJ.
